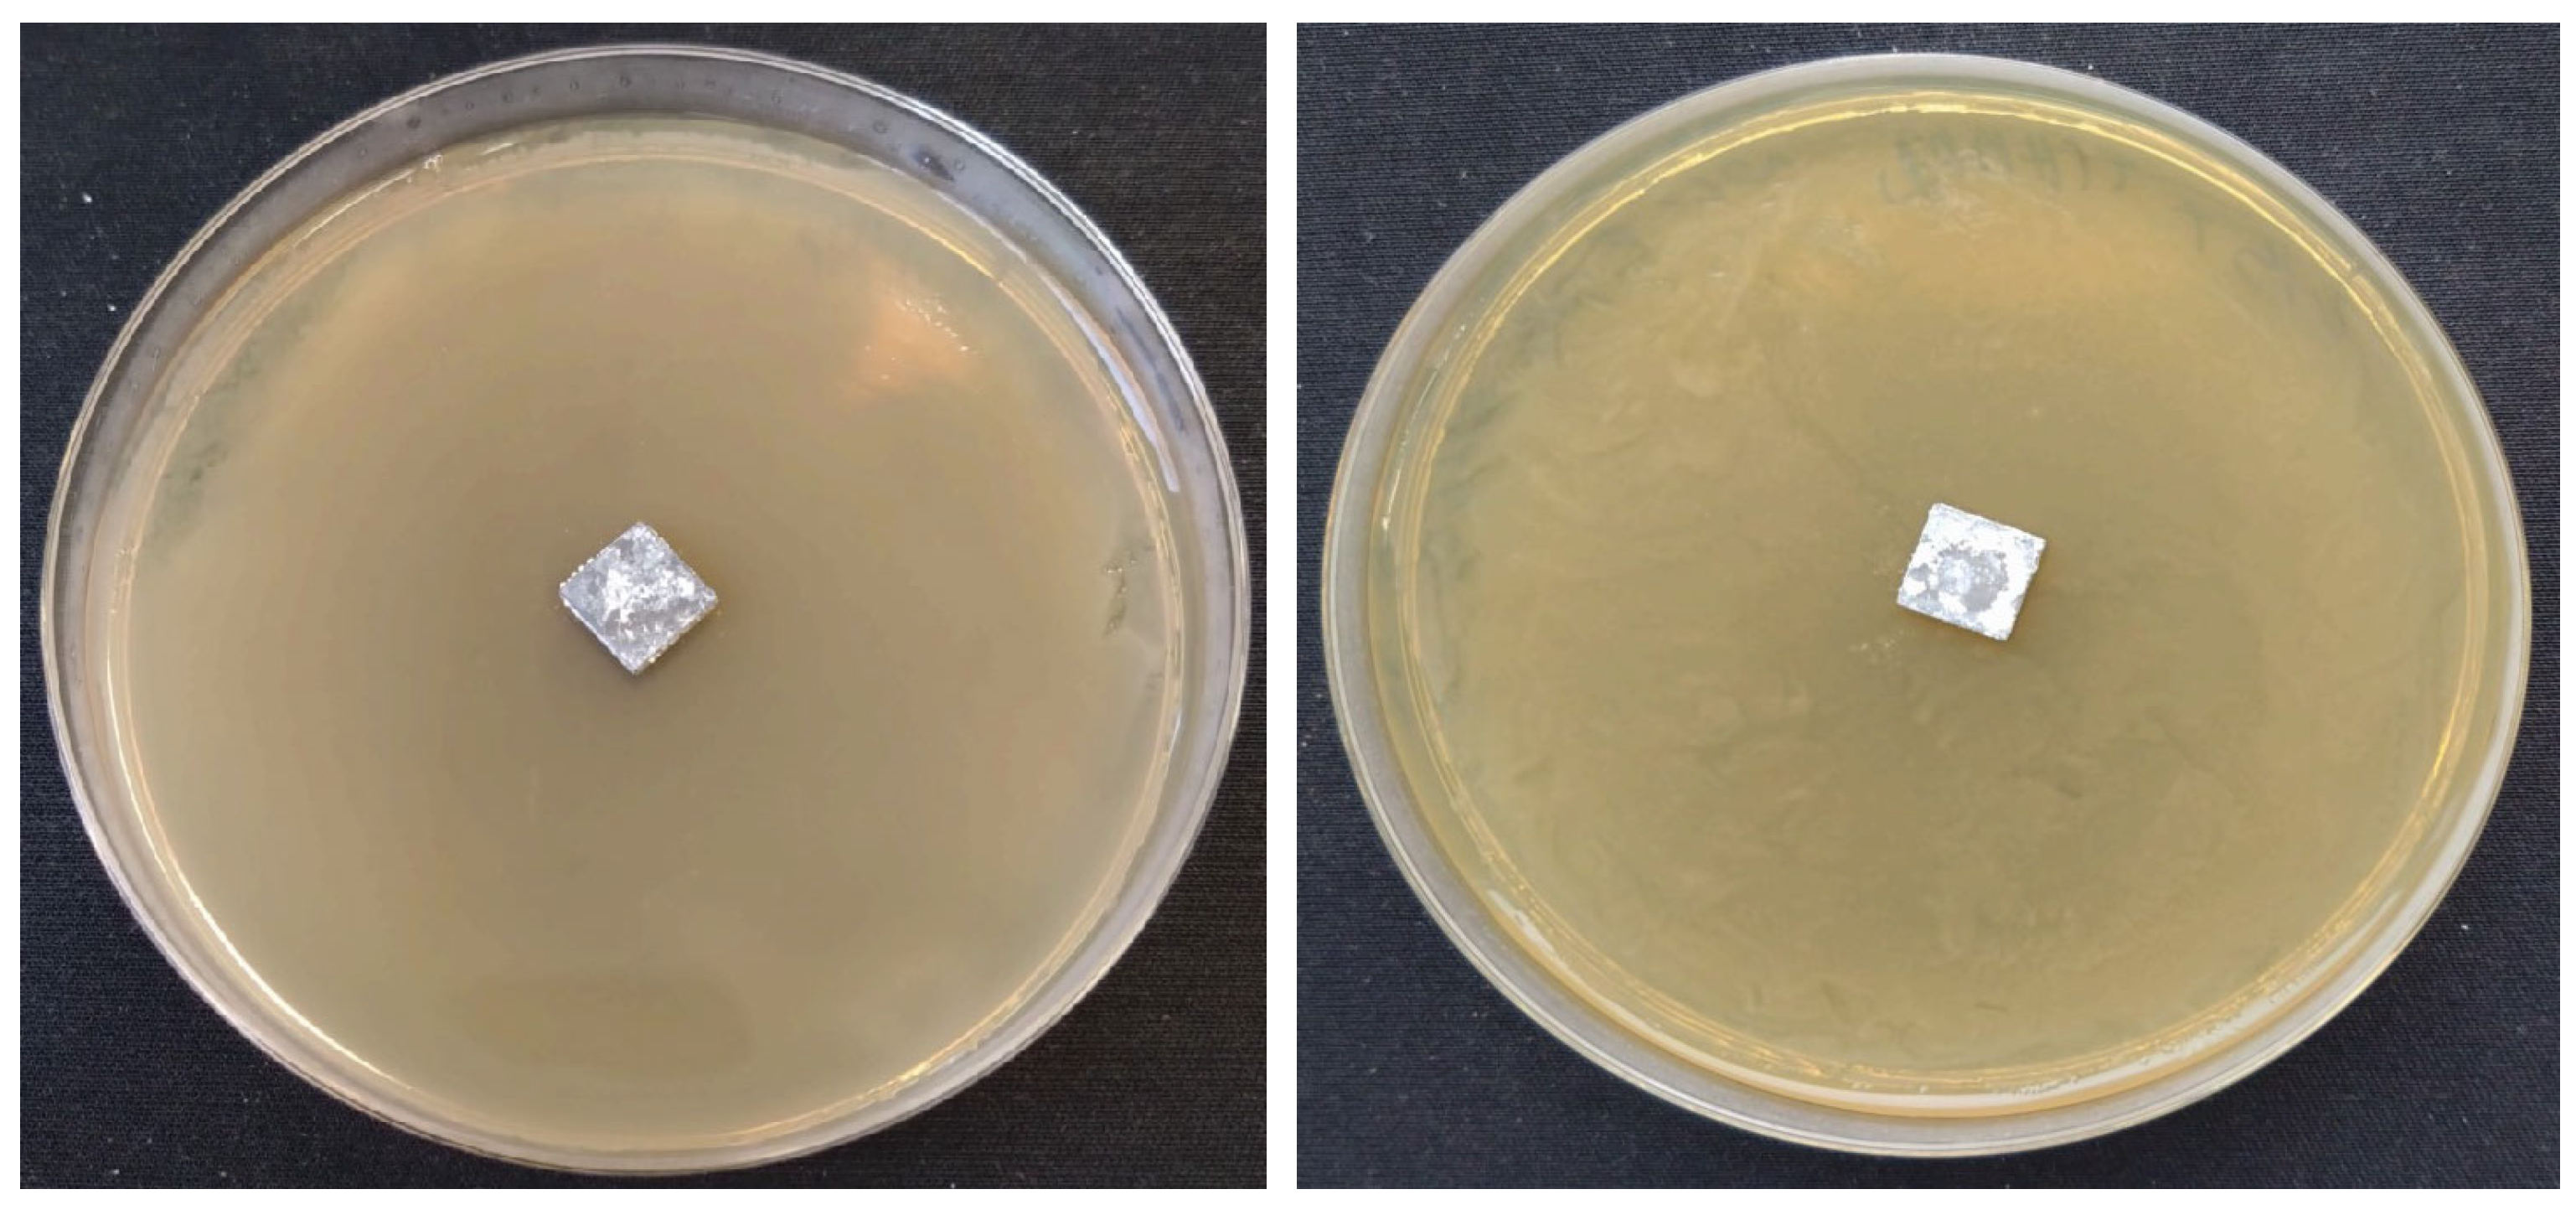
Coatings 13 01991 g008
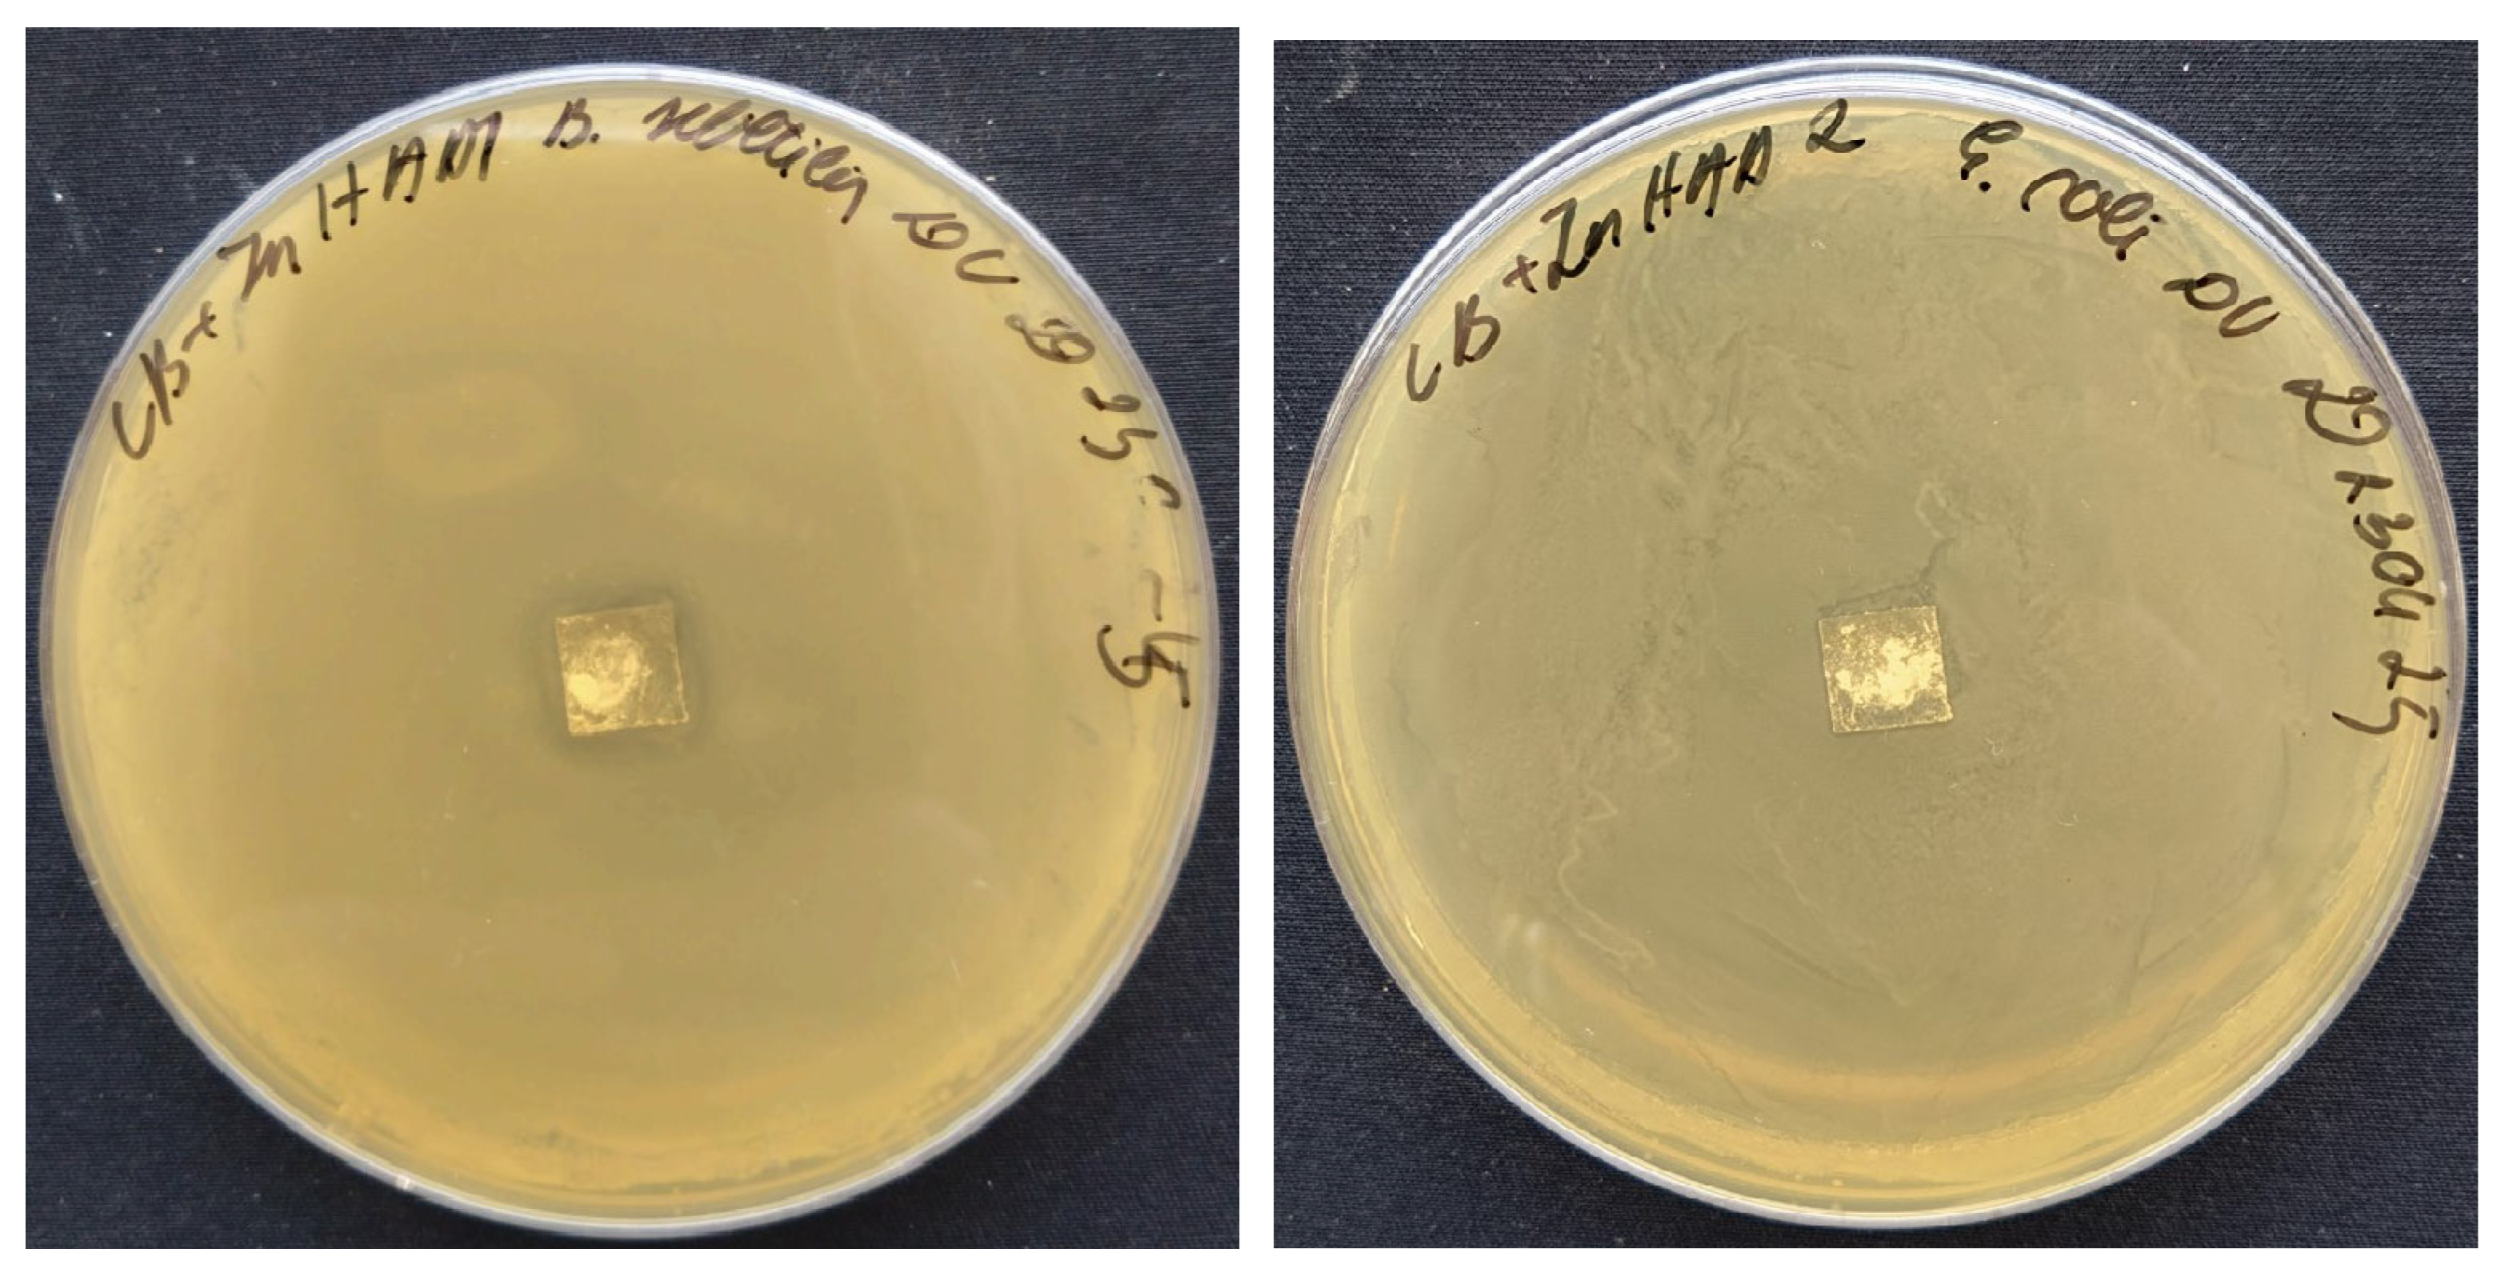
Coatings 13 01991 g010

Calcium Hydroxyapatite Coatings: Low-Temperature Synthesis and Investigation of Antibacterial Properties
Abstract
:1. Introduction
2. Materials and Methods
2.1. Synthesis and Materials
2.1.1. Synthesis of Calcium Carbonate
2.1.2. Synthesis of Calcium Hydroxyapatite
2.1.3. Synthesis of Substituted Calcium Hydroxyapatite
2.2. Characterisation
3. Results
3.1. Synthesis and Characterization of HAP
3.2. Synthesis and Characterization of Cu-HAP
Ca10−xCux(PO4)6(OH)2 + x Cu(OH)2 + 8 NaHCO3 + 2 Na2CO3
3.3. Synthesis and Characterization of Zn-HAP
3.4. SEM and EDX Analysis
3.5. Antibacterial Properties
4. Discussion
- Metal implants. These implants are usually made of titanium or stainless steel and are used for fracture fixation, joint replacement, and spinal surgery [26].
- Ceramic implants. These implants are usually made of zirconium and are used for joint replacement surgery [27].
- Polymer implants. These implants are routinely made of polyethylene and are used for joint replacement surgery, particularly in hips and knees [28].
- Bone grafts. Bone tissue is taken from another part of the patient’s body or from a donor and is used to promote healing of damaged or missing bone [29].
5. Conclusions
Author Contributions
Funding
Institutional Review Board Statement
Informed Consent Statement
Data Availability Statement
Conflicts of Interest
References
- In, Y.; Amornkitbamrung, U.; Hong, M.H.; Shin, H. On the Crystallization of Hydroxyapatite under Hydrothermal Conditions: Role of Sebacic Acid as an Additive. ACS Omega 2020, 5, 27204–27210. [Google Scholar] [CrossRef]
- Szewczyk, A.; Skwira, A.; Ginter, M.; Tajer, D.; Prokopowicz, M. Microwave-Assisted Fabrication of Mesoporous Silica-Calcium Phosphate Composites for Dental Application. Polymers 2020, 13, 53. [Google Scholar] [CrossRef] [PubMed]
- Teotia, A.K.; Raina, D.B.; Singh, C.; Sinha, N.; Isaksson, H.; Tagil, M.; Lidgren, L.; Kumar, A. Nano-Hydroxyapatite Bone Substitute Functionalized with Bone Active Molecules for Enhanced Cranial Bone Regeneration. ACS Appl. Mater. Interfaces 2017, 9, 6816–6828. [Google Scholar] [CrossRef] [PubMed]
- Tas, A.C. Synthesis of biomimetic Ca-hydroxyapatite powders at 37 degrees C in synthetic body fluids. Biomaterials 2000, 21, 1429–1438. [Google Scholar] [CrossRef] [PubMed]
- Kumar, M.; Kumar, R.; Kumar, S. Coatings on orthopedic implants to overcome present problems and challenges: A focused review. Mater. Today Proc. 2021, 45, 5269–5276. [Google Scholar] [CrossRef]
- Cheng, Y.; Zhao, G.; Liu, H. Histological evaluation of collagen-hydroxyapatite composite as osseous implants in the repair of mandibular defect. Chin. J. Reparative Reconstr. Surg. 1998, 12, 74–76. [Google Scholar]
- Park, J.; Kim, B.J.; Hwang, J.Y.; Yoon, Y.W.; Cho, H.S.; Kim, D.H.; Lee, J.K.; Yoon, S.Y. In-Vitro Mechanical Performance Study of Biodegradable Polylactic Acid/Hydroxyapatite Nanocomposites for Fixation Medical Devices. J. Nanosci. Nanotechnol. 2018, 18, 837–841. [Google Scholar] [CrossRef] [PubMed]
- Shi, P.; Liu, M.; Fan, F.; Yu, C.; Lu, W.; Du, M. Characterization of natural hydroxyapatite originated from fish bone and its biocompatibility with osteoblasts. Mater. Sci. Eng. C Mater. Biol. Appl. 2018, 90, 706–712. [Google Scholar] [CrossRef]
- Eliaz, N.; Metoki, N. Calcium Phosphate Bioceramics: A Review of Their History, Structure, Properties, Coating Technologies and Biomedical Applications. Materials 2017, 10, 334. [Google Scholar] [CrossRef]
- Yasukawa, A.; Gotoh, K.; Tanaka, H.; Kandori, K. Preparation and structure of calcium hydroxyapatite substituted with light rare earth ions. Colloids Surf. A: Physicochem. Eng. Asp. 2012, 393, 53–59. [Google Scholar] [CrossRef]
- Lin, K.; Chang, J. Structure and properties of hydroxyapatite for biomedical applications. In Hydroxyapatite (HAp) for Biomedical Applications; Elsevier: Amsterdam, The Netherlands, 2015; pp. 3–19. [Google Scholar]
- Arcos, D.; Vallet-Regi, M. Substituted hydroxyapatite coatings of bone implants. J. Mater. Chem. B 2020, 8, 1781–1800. [Google Scholar] [CrossRef] [PubMed]
- Trinkunaite-Felsen, J. Investigation of Calcium Hydroxyapatite Synthesized Using Natural Precursors. Ph.D. Thesis, Vilnius University, Vilnius, Lithuania, 2014. [Google Scholar]
- Ishikawa, K.; Kareiva, A. Sol–gel synthesis of calcium phosphate-based coatings—A review. Chemija 2020, 31, 25–41. [Google Scholar] [CrossRef]
- Jonauske, V.; Stanionyte, S.; Chen, S.-W.; Zarkov, A.; Juskenas, R.; Selskis, A.; Matijosius, T.; Yang, T.C.; Ishikawa, K.; Ramanauskas, R. Characterization of sol-gel derived calcium hydroxyapatite coatings fabricated on patterned rough stainless steel surface. Coatings 2019, 9, 334. [Google Scholar] [CrossRef]
- Shi, R.; Hayashi, K.; Bang, L.T.; Ishikawa, K. Effects of surface roughening and calcite coating of titanium on cell growth and differentiation. J. Biomater. Appl. 2020, 34, 917–927. [Google Scholar] [CrossRef] [PubMed]
- Yanyan, S.; Guangxin, W.; Wuhui, L.; Yaming, W.; Hayakawa, S.; Osaka, A. Conversion of sub-µm calcium carbonate (calcite) particles to hollow hydroxyapatite agglomerates in K2HPO4 solutions. Nanotechnol. Rev. 2020, 9, 945–960. [Google Scholar] [CrossRef]
- Harris, J.; Mey, I.; Hajir, M.; Mondeshki, M.; Wolf, S.E. Pseudomorphic transformation of amorphous calcium carbonate films follows spherulitic growth mechanisms and can give rise to crystal lattice tilting. CrystEngComm 2015, 17, 6831–6837. [Google Scholar] [CrossRef]
- Gheisari, H.; Karamian, E.; Abdellahi, M. A novel hydroxyapatite—Hardystonite nanocomposite ceramic. Ceram. Int. 2015, 41, 5967–5975. [Google Scholar] [CrossRef]
- Shanmugam, S.; Gopal, B. Copper substituted hydroxyapatite and fluorapatite: Synthesis, characterization and antimicrobial properties. Ceram. Int. 2014, 40, 15655–15662. [Google Scholar] [CrossRef]
- Unabia, R.B.; Bonebeau, S.; Candidato Jr, R.T.; Jouin, J.; Noguera, O.; Pawłowski, L. Investigation on the structural and microstructural properties of copper-doped hydroxyapatite coatings deposited using solution precursor plasma spraying. J. Eur. Ceram. Soc. 2019, 39, 4255–4263. [Google Scholar] [CrossRef]
- Bari, A.; Bloise, N.; Fiorilli, S.; Novajra, G.; Vallet-Regi, M.; Bruni, G.; Torres-Pardo, A.; Gonzalez-Calbet, J.M.; Visai, L.; Vitale-Brovarone, C. Copper-containing mesoporous bioactive glass nanoparticles as multifunctional agent for bone regeneration. Acta Biomater. 2017, 55, 493–504. [Google Scholar] [CrossRef]
- Kalaivani, S.; Singh, R.K.; Ganesan, V.; Kannan, S. Effect of copper (Cu(2+)) inclusion on the bioactivity and antibacterial behavior of calcium silicate coatings on titanium metal. J. Mater. Chem. B 2014, 2, 846–858. [Google Scholar] [CrossRef]
- Chandra, G.; Pandey, A. Biodegradable bone implants in orthopedic applications: A review. Biocybern. Biomed. Eng. 2020, 40, 596–610. [Google Scholar] [CrossRef]
- León, B.; Jansen, J.A. Thin Calcium Phosphate Coatings for Medical Implants; Springer: Berlin/Heidelberg, Germany, 2009; Volume 309. [Google Scholar]
- Prasad, K.; Bazaka, O.; Chua, M.; Rochford, M.; Fedrick, L.; Spoor, J.; Symes, R.; Tieppo, M.; Collins, C.; Cao, A.; et al. Metallic Biomaterials: Current Challenges and Opportunities. Materials 2017, 10, 884. [Google Scholar] [CrossRef]
- Rieu, J.; Goeuriot, P. Ceramic composites for biomedical applications. Clin. Mater. 1993, 12, 211–217. [Google Scholar] [CrossRef]
- Tang, X.; Thankappan, S.K.; Lee, P.; Fard, S.E.; Harmon, M.D.; Tran, K.; Yu, X. Polymeric biomaterials in tissue engineering and regenerative medicine. In Natural and Synthetic Biomedical Polymers; Elsevier: Amsterdam, The Netherlands, 2014; pp. 351–371. [Google Scholar]
- De Long, W.G., Jr.; Einhorn, T.A.; Koval, K.; McKee, M.; Smith, W.; Sanders, R.; Watson, T. Bone grafts and bone graft substitutes in orthopaedic trauma surgery. A critical analysis. J. Bone Jt. Surg. Am. 2007, 89, 649–658. [Google Scholar] [CrossRef]
- Fox, K.; Tran, P.A.; Tran, N. Recent advances in research applications of nanophase hydroxyapatite. Chemphyschem 2012, 13, 2495–2506. [Google Scholar] [CrossRef] [PubMed]
- Siddiqui, H.A.; Pickering, K.L.; Mucalo, M.R. A Review on the Use of Hydroxyapatite-Carbonaceous Structure Composites in Bone Replacement Materials for Strengthening Purposes. Materials 2018, 11, 1813. [Google Scholar] [CrossRef] [PubMed]
- Nasar, A. Hydroxyapatite and its coatings in dental implants. In Applications of Nanocomposite Materials in Dentistry; Elsevier: Amsterdam, The Netherlands, 2019; pp. 145–160. [Google Scholar]
- Jeong, S.H.; Fan, Y.F.; Baek, J.U.; Song, J.; Choi, T.H.; Kim, S.W.; Kim, H.E. Long-lasting and bioactive hyaluronic acid-hydroxyapatite composite hydrogels for injectable dermal fillers: Physical properties and in vivo durability. J. Biomater. Appl. 2016, 31, 464–474. [Google Scholar] [CrossRef] [PubMed]
- Sadat-Shojai, M.; Khorasani, M.T.; Dinpanah-Khoshdargi, E.; Jamshidi, A. Synthesis methods for nanosized hydroxyapatite with diverse structures. Acta Biomater. 2013, 9, 7591–7621. [Google Scholar] [CrossRef] [PubMed]
- Ma, G. Three common preparation methods of hydroxyapatite. Proc. IOP Conf. Ser. Mater. Sci. Eng. 2019, 688, 033057. [Google Scholar] [CrossRef]
- Pu′ad, N.M.; Haq, R.A.; Noh, H.M.; Abdullah, H.; Idris, M.; Lee, T. Synthesis method of hydroxyapatite: A review. Mater. Today Proc. 2020, 29, 233–239. [Google Scholar] [CrossRef]
- Fihri, A.; Len, C.; Varma, R.S.; Solhy, A. Hydroxyapatite: A review of syntheses, structure and applications in heterogeneous catalysis. Coord. Chem. Rev. 2017, 347, 48–76. [Google Scholar] [CrossRef]
- Kalita, S.J.; Verma, S. Nanocrystalline hydroxyapatite bioceramic using microwave radiation: Synthesis and characterization. Mater. Sci. Eng. C Mater. Biol. Appl. 2010, 30, 295–303. [Google Scholar] [CrossRef] [PubMed]
- Lamkhao, S.; Phaya, M.; Jansakun, C.; Chandet, N.; Thongkorn, K.; Rujijanagul, G.; Bangrak, P.; Randorn, C. Synthesis of Hydroxyapatite with Antibacterial Properties Using a Microwave-Assisted Combustion Method. Sci. Rep. 2019, 9, 4015. [Google Scholar] [CrossRef] [PubMed]
- Utara, S.; Klinkaewnarong, J. Effect of sonication time on the characteristics of nanophase hydroxyapatite crystals synthesised by the sol–gel technique. Micro Nano Lett. 2015, 10, 1–4. [Google Scholar] [CrossRef]
- Akram, M.; Ahmed, R.; Shakir, I.; Ibrahim, W.A.W.; Hussain, R. Extracting hydroxyapatite and its precursors from natural resources. J. Mater. Sci. 2014, 49, 1461–1475. [Google Scholar] [CrossRef]
- Sun, R.-X.; Lv, Y.; Niu, Y.-R.; Zhao, X.-H.; Cao, D.-S.; Tang, J.; Sun, X.-C.; Chen, K.-Z. Physicochemical and biological properties of bovine-derived porous hydroxyapatite/collagen composite and its hydroxyapatite powders. Ceram. Int. 2017, 43, 16792–16798. [Google Scholar] [CrossRef]
- Googerdchian, F.; Moheb, A.; Emadi, R.; Asgari, M. Optimization of Pb(II) ions adsorption on nanohydroxyapatite adsorbents by applying Taguchi method. J. Hazard. Mater. 2018, 349, 186–194. [Google Scholar] [CrossRef] [PubMed]
- Khoo, W.; Nor, F.; Ardhyananta, H.; Kurniawan, D. Preparation of natural hydroxyapatite from bovine femur bones using calcination at various temperatures. Procedia Manuf. 2015, 2, 196–201. [Google Scholar] [CrossRef]
- Öksüz, K.E.; Kilinç, S.; Özer, A. Effect of calcination on microstructure development and properties of hydroxyapatite powders extracted from human and bovine bones. Trans. Indian Ceram. Soc. 2019, 78, 41–45. [Google Scholar] [CrossRef]
- Varadavenkatesan, T.; Vinayagam, R.; Pai, S.; Kathirvel, B.; Pugazhendhi, A.; Selvaraj, R. Synthesis, biological and environmental applications of hydroxyapatite and its composites with organic and inorganic coatings. Prog. Org. Coat. 2021, 151, 106056. [Google Scholar] [CrossRef]
- Gopi, D.; Kanimozhi, K.; Bhuvaneshwari, N.; Indira, J.; Kavitha, L. Novel banana peel pectin mediated green route for the synthesis of hydroxyapatite nanoparticles and their spectral characterization. Spectrochim. Acta A Mol. Biomol. Spectrosc. 2014, 118, 589–597. [Google Scholar] [CrossRef] [PubMed]
- Gopi, D.; Kanimozhi, K.; Kavitha, L. Opuntia ficus indica peel derived pectin mediated hydroxyapatite nanoparticles: Synthesis, spectral characterization, biological and antimicrobial activities. Spectrochim. Acta A Mol. Biomol. Spectrosc. 2015, 141, 135–143. [Google Scholar] [CrossRef]
- Begum, Y.; Deka, S. Green synthesis of pectin mediated hydroxyapatite nanoparticles from culinary banana bract and its characterization. Acta Aliment. 2017, 46, 428–438. [Google Scholar] [CrossRef]
- Yamaguchi, M.; Oishi, H.; Suketa, Y. Stimulatory effect of zinc on bone formation in tissue culture. Biochem. Pharmacol. 1987, 36, 4007–4012. [Google Scholar] [CrossRef]
- Yamaguchi, M. Role of zinc in bone formation and bone resorption. J. Trace Elem. Exp. Med. Off. Publ. Int. Soc. Trace Elem. Res. Hum. 1998, 11, 119–135. [Google Scholar] [CrossRef]
- Webster, T.J.; Massa-Schlueter, E.A.; Smith, J.L.; Slamovich, E.B. Osteoblast response to hydroxyapatite doped with divalent and trivalent cations. Biomaterials 2004, 25, 2111–2121. [Google Scholar] [CrossRef] [PubMed]
- Bulina, N.V.; Eremina, N.V.; Vinokurova, O.B.; Ishchenko, A.V.; Chaikina, M.V. Diffusion of Copper Ions in the Lattice of Substituted Hydroxyapatite during Heat Treatment. Materials 2022, 15, 5759. [Google Scholar] [CrossRef]
- Othmani, M.; Bachoua, H.; Ghandour, Y.; Aissa, A.; Debbabi, M. Synthesis, characterization and catalytic properties of copper-substituted hydroxyapatite nanocrystals. Mater. Res. Bull. 2018, 97, 560–566. [Google Scholar] [CrossRef]
- Jacobs, A.; Renaudin, G.; Forestier, C.; Nedelec, J.M.; Descamps, S. Biological properties of copper-doped biomaterials for orthopedic applications: A review of antibacterial, angiogenic and osteogenic aspects. Acta Biomater. 2020, 117, 21–39. [Google Scholar] [CrossRef]
- Chellan, P.; Sadler, P.J. The elements of life and medicines. Philos. Trans. A Math. Phys. Eng. Sci. 2015, 373, 20140182. [Google Scholar] [CrossRef] [PubMed]
- Opsahl, W.; Zeronian, H.; Ellison, M.; Lewis, D.; Rucker, R.B.; Riggins, R.S. Role of copper in collagen cross-linking and its influence on selected mechanical properties of chick bone and tendon. J. Nutr. 1982, 112, 708–716. [Google Scholar] [CrossRef] [PubMed]
- Lowe, N.M.; Lowe, N.M.; Fraser, W.D.; Jackson, M.J. Is there a potential therapeutic value of copper and zinc for osteoporosis? Proc. Nutr. Soc. 2002, 61, 181–185. [Google Scholar] [CrossRef]
- Ingle, A.P.; Paralikar, P.; Shende, S.; Gupta, I.; Biswas, J.K.; da Silva Martins, L.H.; Rai, M. Copper in medicine: Perspectives and toxicity. In Biomedical Applications of Metals; Springer: Berlin/Heidelberg, Germany, 2018; pp. 95–112. [Google Scholar]
- Prado, J.V.; Esparza, M.M.; Vidal, A.R.; Duran, T.C. Adherence to copper and stainless steel metal coupons of common nosocomial bacterial strains. Rev. Med. Chil. 2013, 141, 291–297. [Google Scholar] [CrossRef]
- Salgado, C.D.; Sepkowitz, K.A.; John, J.F.; Cantey, J.R.; Attaway, H.H.; Freeman, K.D.; Sharpe, P.A.; Michels, H.T.; Schmidt, M.G. Copper surfaces reduce the rate of healthcare-acquired infections in the intensive care unit. Infect. Control Hosp. Epidemiol. 2013, 34, 479–486. [Google Scholar] [CrossRef] [PubMed]
- Prather, V. Copper, brass and bronze kill pathogens-including "superbug" MRSA-responsible for hospital- and community-acquired infections. CDA Press Release 2008, 25, 1. [Google Scholar]
- Dorozhkin, S.V. Calcium orthophosphates. J. Mater. Sci. 2007, 42, 1061–1095. [Google Scholar] [CrossRef]
- Stanić, V.; Dimitrijević, S.; Antić-Stanković, J.; Mitrić, M.; Jokić, B.; Plećaš, I.B.; Raičević, S. Synthesis, characterization and antimicrobial activity of copper and zinc-doped hydroxyapatite nanopowders. Appl. Surf. Sci. 2010, 256, 6083–6089. [Google Scholar] [CrossRef]
- Bhattacharjee, A.; Fang, Y.; Hooper, T.J.N.; Kelly, N.L.; Gupta, D.; Balani, K.; Manna, I.; Baikie, T.; Bishop, P.T.; White, T.J.; et al. Crystal Chemistry and Antibacterial Properties of Cupriferous Hydroxyapatite. Materials 2019, 12, 1814. [Google Scholar] [CrossRef] [PubMed]
- Huang, Y.; Zhang, X.; Zhao, R.; Mao, H.; Yan, Y.; Pang, X. Antibacterial efficacy, corrosion resistance, and cytotoxicity studies of copper-substituted carbonated hydroxyapatite coating on titanium substrate. J. Mater. Sci. 2015, 50, 1688–1700. [Google Scholar] [CrossRef]
- Wolf-Brandstetter, C.; Beutner, R.; Hess, R.; Bierbaum, S.; Wagner, K.; Scharnweber, D.; Gbureck, U.; Moseke, C. Multifunctional calcium phosphate based coatings on titanium implants with integrated trace elements. Biomed. Mater. 2020, 15, 025006. [Google Scholar] [CrossRef] [PubMed]
- Nan, L.; Liu, Y.; Lu, M.; Yang, K. Study on antibacterial mechanism of copper-bearing austenitic antibacterial stainless steel by atomic force microscopy. J. Mater. Sci. Mater. Med. 2008, 19, 3057–3062. [Google Scholar] [CrossRef] [PubMed]
- Thakur, A.; Sharma, S.; Ganjoo, R.; Assad, H.; Kumar, A. Anti-Corrosive Potential of the Sustainable Corrosion Inhibitors Based on Biomass Waste: A Review on Preceding and Perspective Research. J. Phys. Conf. Series 2022, 2267, 012079. [Google Scholar] [CrossRef]
- Hikku, G.S.; Arthi, C.; Jeen Robert, R.B.; Jeyasubramanian, K.; Murugesan, R. Calcium phosphate conversion technique: A versatile route to develop corrosion resistant hydroxyapatite coating over Mg/Mg alloys based implants. J. Magnes. Alloys 2022, 10, 1821–1845. [Google Scholar] [CrossRef]
- Singh, J.; Singh Chatha, S.; Singh, H. Microstructural and in-vitro characteristics of functional calcium silicate topcoat on hydroxyapatite coating for bio-implant applications. Prog. Biomater. 2022, 11, 95–108. [Google Scholar] [CrossRef]

Disclaimer/Publisher’s Note: The statements, opinions and data contained in all publications are solely those of the individual author(s) and contributor(s) and not of MDPI and/or the editor(s). MDPI and/or the editor(s) disclaim responsibility for any injury to people or property resulting from any ideas, methods, instructions or products referred to in the content. |
© 2023 by the authors. Licensee MDPI, Basel, Switzerland. This article is an open access article distributed under the terms and conditions of the Creative Commons Attribution (CC BY) license (https://creativecommons.org/licenses/by/4.0/).
Share and Cite
Lukaviciute, L.; Karciauskaite, J.; Grigoraviciute, I.; Vasiliauskiene, D.; Sokol, D.; Kareiva, A. Calcium Hydroxyapatite Coatings: Low-Temperature Synthesis and Investigation of Antibacterial Properties. Coatings 2023, 13, 1991. https://doi.org/10.3390/coatings13121991
Lukaviciute L, Karciauskaite J, Grigoraviciute I, Vasiliauskiene D, Sokol D, Kareiva A. Calcium Hydroxyapatite Coatings: Low-Temperature Synthesis and Investigation of Antibacterial Properties. Coatings. 2023; 13(12):1991. https://doi.org/10.3390/coatings13121991
Chicago/Turabian StyleLukaviciute, Laura, Justina Karciauskaite, Inga Grigoraviciute, Dovile Vasiliauskiene, Denis Sokol, and Aivaras Kareiva. 2023. "Calcium Hydroxyapatite Coatings: Low-Temperature Synthesis and Investigation of Antibacterial Properties" Coatings 13, no. 12: 1991. https://doi.org/10.3390/coatings13121991
APA StyleLukaviciute, L., Karciauskaite, J., Grigoraviciute, I., Vasiliauskiene, D., Sokol, D., & Kareiva, A. (2023). Calcium Hydroxyapatite Coatings: Low-Temperature Synthesis and Investigation of Antibacterial Properties. Coatings, 13(12), 1991. https://doi.org/10.3390/coatings13121991

